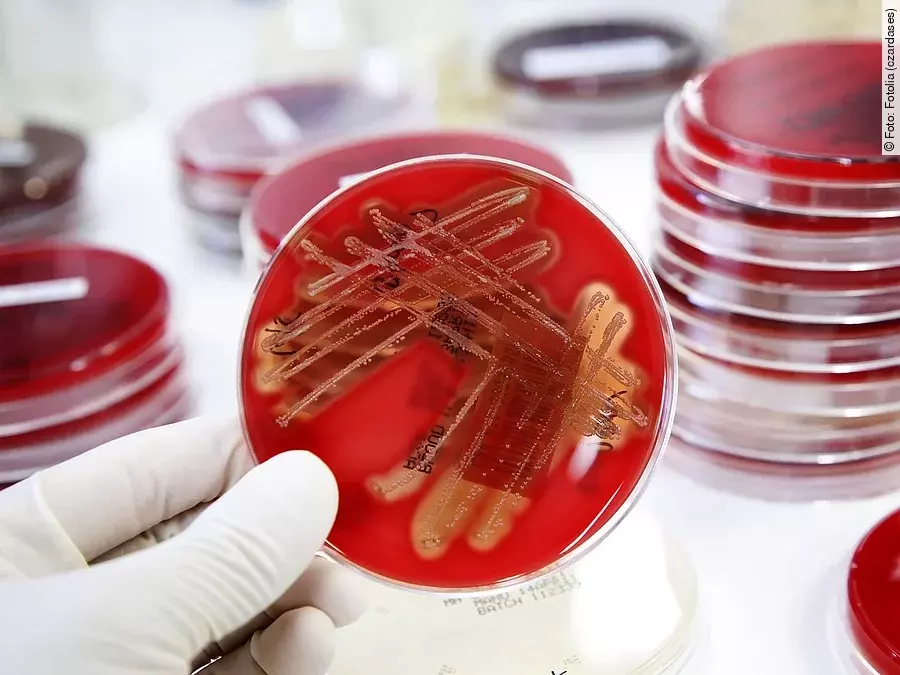
Bakterien

Die Ermittlungen richteten sich gegen unbekannt, sagte Oberstaatsanwalt Ulrich Bremer am Mittwoch der Deutschen Presse-Agentur. Zudem untersuche man weiter, ob der Tod eines 84-Jährigen Mitte April mit einer Infektion mit dem Erreger «Pseudomonas aeruginosa» zusammenhängt.
Der Erreger wurde in der Praxis entdeckt und kann unter anderem Lungenentzündungen sowie Harnwegs- und Wundinfektionen verursachen. Zur Infektion benötigt der Erreger meist eine Eintrittsstelle in den menschlichen Körper, etwa eine Wunde, einen Katheter - oder eine Spritze.
Zeugenbefragung steht aus
Die Fahnder hätten bereits Akten der 28 Patienten in der Praxis und bei weiteren behandelnden Ärzten sichergestellt, sagte Bremer. Diese soll nun ein Gutachter prüfen. Zudem sollten demnächst zahlreiche Zeugen vernommen werden, die Patienten seien kontaktiert worden.
Sie hatten in der Praxis Spritzen in den Rücken bekommen und waren nach der Behandlung erkrankt, manche von ihnen schwer. Der inzwischen verstorbene Rentner hatte sich nach Angaben der Staatsanwaltschaft zu Jahresbeginn wegen Rückenproblemen behandeln lassen. Nachdem er eine Spritze erhalten hatte, sei es wiederholt zu Komplikationen gekommen. Nach einer Operation starb er Mitte April an Multiorganversagen. Laut Staatsanwaltschaft war der Keim bei der Obduktion gefunden worden.
Sollten sich tatsächlich insgesamt 29 Patienten mit dem Erreger infiziert haben, wäre es «meines Wissens einer der schwerwiegendsten Vorfälle mit diesem Erreger in einer ambulanten Einrichtung in Deutschland, wenn nicht sogar in Europa», sagte der Infektiologe Peter Walger nach Bekanntwerden des Falls. Walger ist Vorstandssprecher der Deutschen Gesellschaft für Krankenhaushygiene.







Derzeit sind noch keine Kommentare vorhanden. Schreiben Sie den ersten Kommentar!
Jetzt einloggen